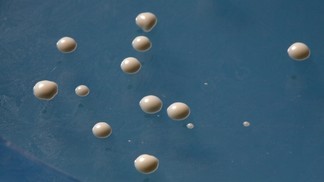
Yeast � Alain Herzog

Yeast
Yeast
An anti-inflammation drug's well-kept secrets have finally been uncovered thanks to a type of yeast; a discovery that will impact treatments for other diseases and limit side effects. Sulfasalazine is a frequently used drug, but its anti-inflammation mechanism has remained, to date, poorly understood. However, a team from EPFL's Laboratory of Protein Engineering has now been able to elucidate this mystery. They have identified the specific protein that is inhibited by the treatment. The results, published online on the 17th April, open the way to new applications and complementary treatments that will reduce side-effects. The goal of this research was to identify those proteins that are targeted by drugs. In order to achieve this, the scientists used yeast.
TO READ THIS ARTICLE, CREATE YOUR ACCOUNT
And extend your reading, free of charge and with no commitment.
Your Benefits
- Access to all content
- Receive newsmails for news and jobs
- Post ads